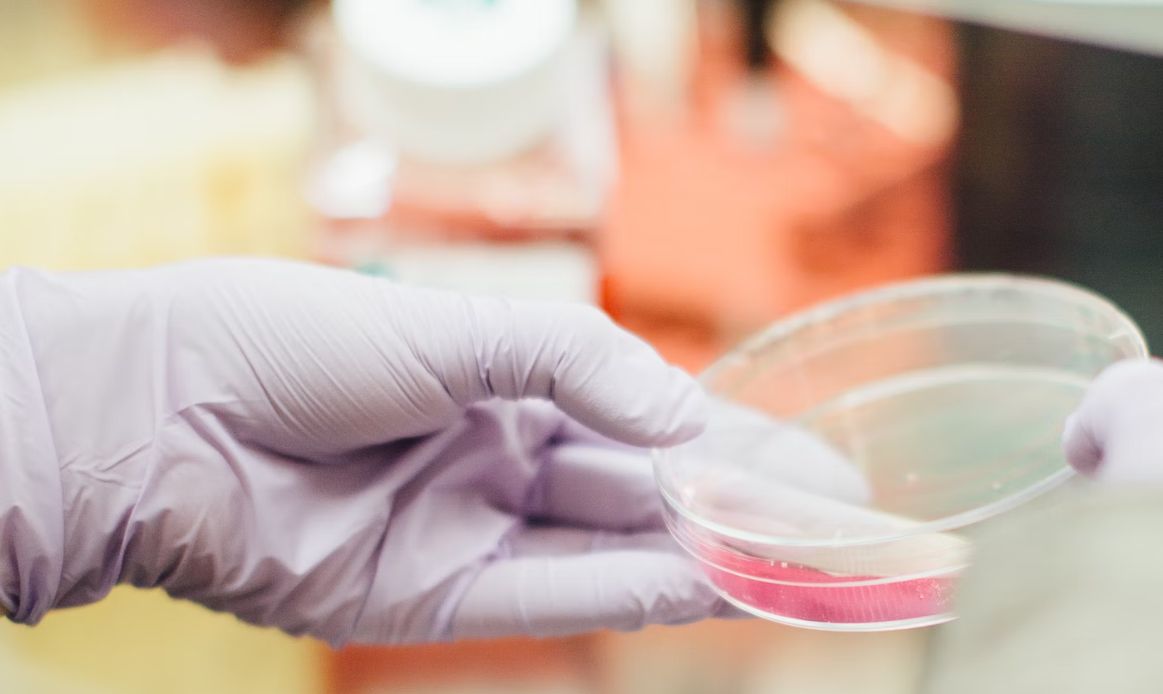

Специалисты государственной корпорации «Ростех» работают над прототипом общевойскового универсального экзоскелета для нужд ВС РФ. Об этом сообщил первый заместитель генерального директора «Ростеха» Владимир Артяков.
Новый экзоскелет будет покрывать все тело российского военнослужащего и иметь модульную конструкцию, сообщил Владимир Артяков в интервью РИА Новости.
«Такой экзокомплекс значительно повышает эффективность бойца. Снижает энергетические затраты и повышает точность стрельбы из автоматического оружия», — подчеркнул спикер.
По словам Артякова, модули нового экзоскелета состоят из очень прочных композитных материалов и при необходимости допускают «экстренный сброс».